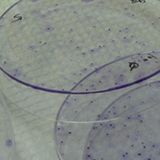

Other commentsSign in to post comments. You don't have an account? Sign up now!
Related posts
Dear colleagues
you can follow me on LinkedIn.com through this link.
https://www.linkedin.com/in/fatemeh-kourkinejad-gharaeiWhat are the primary symptoms associated with sleep disorders like insomnia, sleep apnea, and narcolepsy, and what strategies can be used to overcome these conditions?monochorionic pregnancyBone Marrow Transplant Procedure, Uses and BenefitsSymptoms of appendicitis
Scope of practice of NREMTSuturingWhich is reference better for biochemistry for first year
Scope of practice of NREMTSuturingWhich is reference better for biochemistry for first year